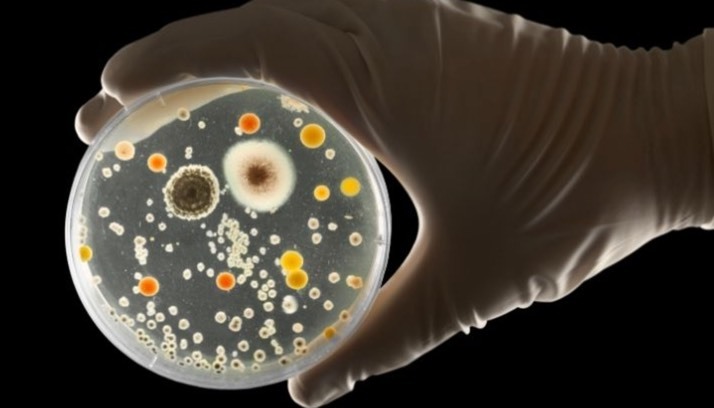
بیشتر عفونت‌های «بیمارستانی» از اینجا می‌آید!

یکسری از عفونتهای در طی بستری بیمار در بیمارستان ایجاد میشوند، دانستن اینکه منشا آنها کجاست و از کجا ناشی میشوند، بسیار مهم است. با بررسی دادههای ژنتیکی از باکتریهای ایجادکننده این عفونتها – مثلا E. coli – مشخشص شده که بیشتر عفونتهای بیمارستانی ناشی از باکتریهایی هستند که قبلاً بیخطر بودند که بیماران حتی قبل از ورود به بیمارستان روی بدن خود داشتند.
به گزارش مجله سلامت صد آنلاین، یک سری از عفونتهای در طی بستری بیمار در بیمارستان ایجاد میشوند، دانستن اینکه منشا آنها کجاست و از کجا ناشی میشوند، بسیار مهم است.
با بررسی دادههای ژنتیکی از باکتریهای ایجادکننده این عفونتها – مثلا E. coli – مشخشص شده که بیشتر عفونتهای بیمارستانی ناشی از باکتریهایی هستند که قبلاً بیخطر بودند که بیماران حتی قبل از ورود به بیمارستان روی بدن خود داشتند.
تحقیقاتی که در مورد مقایسه باکتریهای موجود در میکروبیوم – آنهایی که در بینی، پوست و سایر نواحی بدن ما به صورت طبیعی وجود دارند – با باکتریهایی که باعث ذاتالریه، اسهال، عفونتهای جریان خون و عفونتهای محل جراحی میشوند، نشان میدهد که باکتریهایی که در بدن ما به صورت سالم وجود داشتند، بیشتر اوقات مسئول عفونتهای بیمارستانی میشوند.

مثلا بسیاری از عفونتهای محل جراحی پس از جراحی ستون فقرات توسط میکروبهایی ایجاد میشوند که از قبل روی پوست بیمار هستند.
در میان انواع مختلف عفونتهای مرتبط با مراقبتهای بهداشتی، عفونتهای محل جراحی مشکل ساز هستند. مطالعهای در سال ۲۰۱۳ نشان داد که عفونتهای محل جراحی بیشترین سهم را در هزینههای سالانه عفونتهای بیمارستانی دارد، که در مجموع بیش از ۳۳ درصد از ۸.۹ میلیارد دلار آمریکا هزینه در بر داشتهاند.
عفونتهای محل جراحی در ضمن یکی از دلایل مهم بستری مجدد در بیمارستان و مرگ پس از جراحی است.
بیمارستانها برای جلوگیری از این عفونتها تلاشهای فوقالعادهای انجام میدهند. این موارد شامل استریل کردن تمام تجهیزات جراحی، استفاده از نور ماوراء بنفش برای تمیز کردن اتاق عمل، پیروی از پروتکلهای سختگیرانه برای لباس جراحی و نظارت بر جریان هوا در اتاق عمل است.
با این حال، عفونتهای محل جراحی باز هم رخ میدهنذ و مشکل عفونت محل جراحی بهتر نمیشود.
در واقع، از آنجایی که تجویز آنتی بیوتیک در حین جراحی سنگ بنای پیشگیری از عفونت است، افزایش جهانی مقاومت آنتی بیوتیکی برای افزایش نرخ عفونت پس از جراحی پیشبینی میشود.
مطالعات قبلی در مورد عفونت محل جراحی محدود به یک گونه از باکتریها بوده و از روشهای تجزیه و تحلیل ژنتیکی قدیمیتر استفاده شده بود. اما فنآوریهای جدید راه را برای مطالعه همه انواع باکتریها و آزمایش ژنهای مقاومت آنتیبیوتیکی آنها به طور همزمان باز کرده است.
در تحقیق جدید محققان به چند دلیل روی عفونت در جراحی ستون فقرات تمرکز کردند. اولاً، تعداد مشابهی از زنان و مردان به دلایل مختلف در طول زندگی خود تحت عمل جراحی ستون فقرات قرار میگیرند، به این معنی که نتایج ما برای گروه بزرگتری از افراد قابل استفاده است.

دوم، منابع مراقبتهای بهداشتی بیشتری نسبت به هر نوع روش جراحی دیگری در ایالات متحده صرف جراحی ستون فقرات میشود..
در طی یک دوره یک ساله، محققان از باکتریهای ساکن در بینی، پوست و مدفوع بیش از ۲۰۰ بیمار قبل از جراحی نمونهبرداری کردند. سپس این گروه را به مدت ۹۰ روز دنبال کردیم تا آن نمونهها را با هر گونه عفونتی که بعداً رخ داده است مقایسه کنند.
نتایج ما نشان داد کهبا اینکه گونههای باکتریایی که در پوست پشت بیماران زندگی میکنند بین افراد بهطور قابلتوجهی متفاوت است، برخی الگوهای واضح وجود دارد. باکتریهایی که قسمت بالایی پشت اطراف گردن وشانهها را تشکیل میدهند بیشتر شبیه باکتریهای موجود در بینی هستند. آنهایی که معمولاً در قسمت پایین کمر وجود دارند بیشتر شبیه به آنهایی هستند که در روده و مدفوع هستند.
در واقع، ۸۶ درصد از باکتریهایی که پس از جراحی ستون فقرات باعث عفونت میشوند، از نظر ژنتیکی با باکتریهایی که بیمار قبل از جراحی حمل میکرد، مطابقت داشتند. این عدد به طور قابل توجهی نزدیک به تخمینهای مطالعات قبلی با استفاده از تکنیکهای ژنتیکی قدیمیتر متمرکز بر استافیلوکوکوس اورئوس است.
نزدیک به ۶۰ درصد عفونتها همچنین به آنتی بیوتیکهای پیشگیرانه تجویز شده در حین جراحی، ضد عفونیکنندهای که برای تمیز کردن پوست قبل از برش یا هر دو استفاده میشود، مقاوم بودند.
به نظر میرسد منبع این مقاومت آنتی بیوتیکی نیز در بیمارستان نبوده، بلکه از میکروبهایی است که بیمار قبلاً ناآگاهانه با آنها زندگی میکرده است. آنها احتمالاً این میکروبهای مقاوم به آنتی بیوتیک را از طریق قرار گرفتن در معرض آنتی بیوتیک قبلی، محصولات مصرفی یا تماس معمول با جامعه به دست آوردهاند.
پیشگیری از عفونتهای جراحی
اگر محتملترین منبع عفونت جراحی – میکروبیوم بیمار – باشد، این فرصتی را برای تیمهای پزشکی فراهم میکند تا قبل از انجام یک روش برنامهریزی شده در برابر آن محافظت کنند. پروتکلهای کنونی برای پیشگیری از عفونت، مانند آنتیبیوتیکها یا ضد عفونیکنندههای موضعی، یا آنتیبیوتیک سفازولین برای هر بیمار با شخصیسازی شدن، موثرتر میشوند.
اگر امروز یک عمل جراحی بزرگ انجام میدادید، هیچ کس نمیدانست که آیا محل برش شما با باکتریهای مقاوم به رژیم استاندارد آنتیبیوتیک برای آن روش کلون شده است یا خیر. در آینده، پزشکان میتوانند از اطلاعات میکروبیوم شما برای انتخاب داروهای ضد میکروبی هدفمندتر استفاده کنند. اما تحقیقات بیشتری در مورد چگونگی تفسیر این اطلاعات و درک اینکه آیا چنین رویکردی در نهایت منجر به نتایج بهتری میشود، مورد نیاز است.
این واقعیت که بیشتر عفونتها در واقع با منابعی در بیمارستان شروع نمیشوند، احتمالاً شاهدی بر اثربخشی این پروتکلها است.